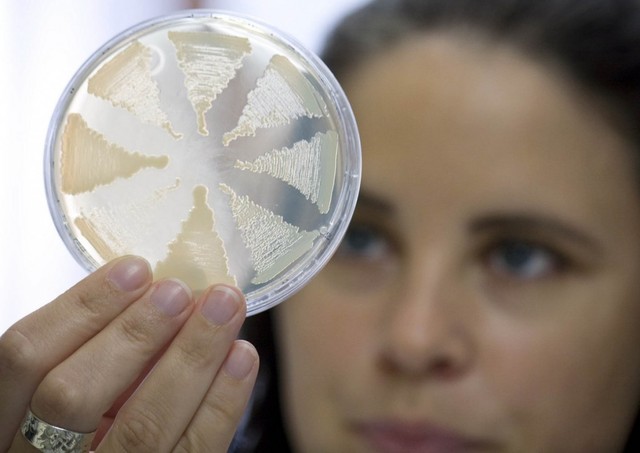
Опасно для жизни! Минздрав сообщил об отсутствии препаратов от ботулизма

Об этом сообщает пресс-служба Министерства здравоохранения.
"Такая ситуация связана с тем, что в 2014 году закончилось действие сертификата о государственной регистрации "Сыворотки противоботулинической типов А, В, E лошадиной очищенной концентрированной жидкой", и до сих пор от заявителя - юридического или физического лица, которое отвечает за эффективность, качество и безопасность лекарственного средства не поступали документы для процедуры регистрации / перерегистрации этого лекарственного средства.
Минздрав неоднократно обращался к потенциальным заявителям и производителям упомянутых препаратов относительно возможности инициации государственной регистрации препаратов на территории Украины. Однако, согласно действующему законодательству, ни Министерство, ни структурные подразделения по вопросам охраны здоровья не могут закупать эти лекарственные средства, пока они не будут зарегистрированы", - говорится в сообщении.
Выходом из сложившейся ситуации может быть закупка необходимых препаратов через международные организации.
Учитывая обострение эпидемической ситуации и отсутствие зарегистрированных лекарственных средств для осуществления неотложных мероприятий по профилактике и лечению ботулизма Минздрав обратился к международным организациям с просьбой оказать гуманитарную помощь в медицинских иммунобиологических препаратах. По возможности, необходимые препараты будут поставлены в кратчайшие сроки.
Минздрав подготовил расчеты бюджетной программы "Обеспечение медицинских мероприятий отдельных государственных программ и комплексных мероприятий программного характера" по направлению "Централизованная закупка медикаментов для больных инфекционными заболеваниями, сопровождающиеся высоким уровнем летальности (дифтерия, бешенство, столбняк, ботулизм, малярия)". Закупка необходимых для лечения этих заболеваний лекарственные средств станет возможной после внесения изменений в госбюджет на 2017 год.